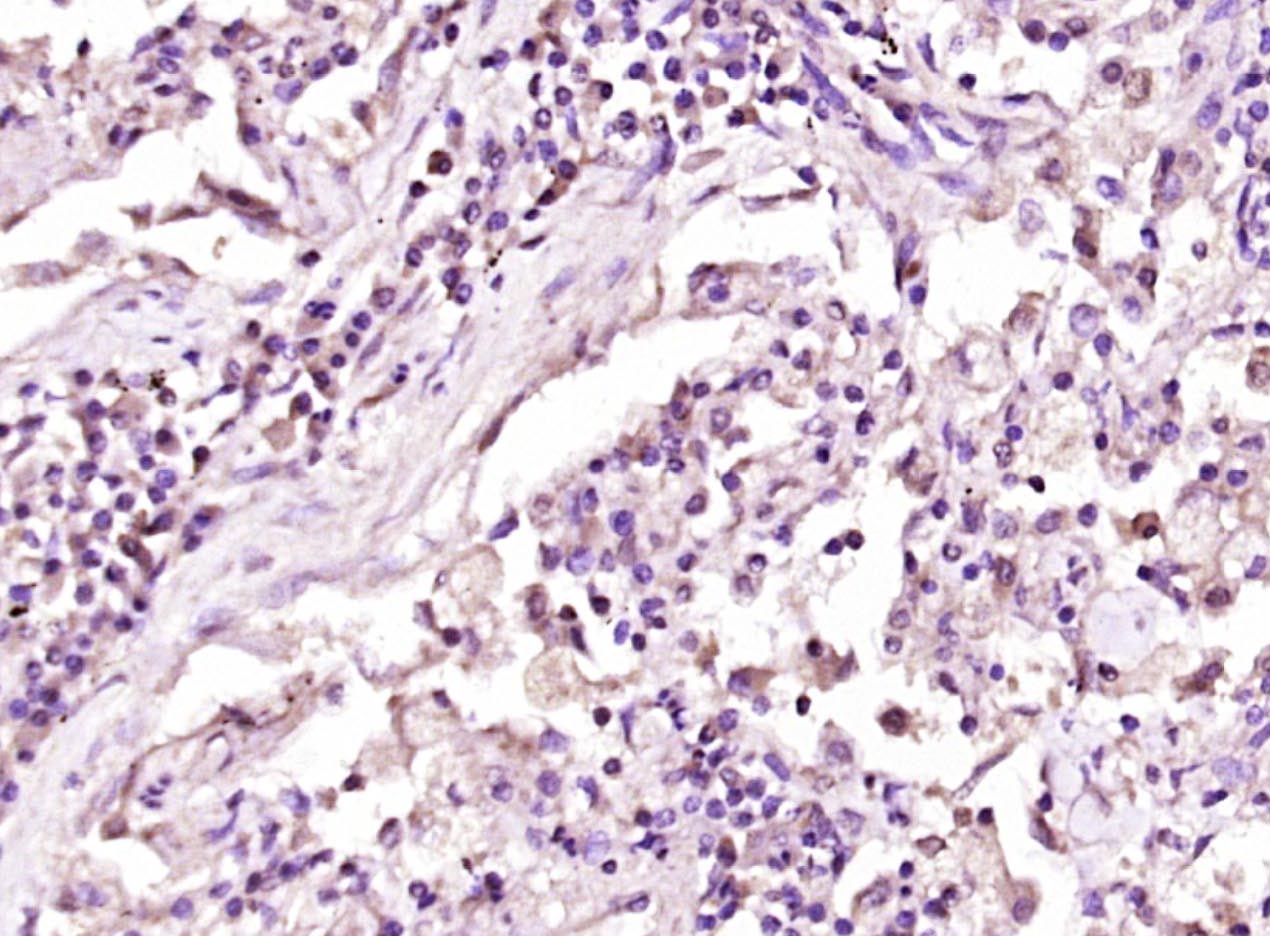
phospho-Dishevelled 2 (Thr224)

相关产品推荐更多 >

SDHB Rabbit pAb, RBITC conjugated(bs-6650R-RBITC)-100ul
¥2980
CTRP6 Rabbit pAb, AP conjugated(bs-14104R-AP)-100ul
¥2980
Fibrinogen alpha chain Rabbit pAb, HRP conjugated(bs-7548R-HRP)-100ul
¥2980
VHL Rabbit pAb, APC-Cy5.5 conjugated(bs-1367R-APC-Cy5.5)-100ul
¥2980
Myoglobin Rabbit pAb(bs-41107R)-50ul/100ul/200ul
¥1180
万千商家帮你免费找货
0 人在求购买到急需产品
- 详细信息
- 技术资料
- 应用范围:
产品信息以Bioss网站为准
- 规格:
50ul/100ul/200ul
| 规格: | 50ul | 产品价格: | ¥1180.0 |
|---|---|---|---|
| 规格: | 100ul | 产品价格: | ¥1980.0 |
| 规格: | 200ul | 产品价格: | ¥2800.0 |
| 产品编号 | bs-9060R |
| 英文名称 | phospho-Dishevelled 2 (Thr224) Rabbit pAb |
| 中文名称 | 磷酸化蓬乱蛋白2抗体 |
| 英文别名 | Dishevelled 2(phospho T224); Dishevelled 2(phospho Thr224); p-Dishevelled 2(Thr224); p-Dishevelled 2(T224); Dishevelled 2(homologous to Drosophila dsh); Dishevelled dsh homolog 2; Dishevelled-2; Dishevelled2; DSH homolog 2; DVL 2; Dvl2; DVL2_HUMAN; Segment polarity protein dishevelled homolog DVL 2; Segment polarity protein dishevelled homolog DVL-2; Segment polarity protein dishevelled homolog DVL2. |
| 产品应用 | IHC-P=1:100-500, IHC-F=1:100-500, IF=1:100-500 Not yet tested in other applications. |
| 交叉反应 | Human (Mouse, Rat, Chicken, Dog, Pig, Cow, Horse, Sheep) |
| 抗体来源 | Rabbit |
| 免疫原 | KLH conjugated synthesised phosphopeptide derived from human DVL2 around the phosphorylation site of Thr224 |
| 亚型 | IgG |
| 性状 | Liquid |
| 纯化方法 | affinity purified by Protein A |
| 克隆类型 | Polyclonal |
| 理论分子量 | 79 kDa |
| 浓度 | 1mg/ml |
| 储存液 | 0.01M TBS (pH7.4) with 1% BSA, 0.02% Proclin300 and 50% Glycerol. |
| 研究领域 | Stem Cells > Signaling Pathways > Notch > Cytoplasmic Stem Cells > Signaling Pathways > Wnt > Cytoplasmic |
| 亚基 | Interacts through its PDZ domain with the C-terminal regions of VANGL1 and VANGL2. Interacts with Rac. Interacts with ARRB1; the interaction is enhanced by phosphorylation of DVL1. Can form large oligomers (via DIX domain). Interacts (via DIX domain) with DIXDC1 (via DIX domain). Interacts (via DEP domain) with AP2M1 and the AP-2 complex. Interacts with DACT1. |
| 亚细胞定位 | Cell membrane; Peripheral membrane protein; Cytoplasmic side. Cytoplasm, cytosol. Cytoplasmic vesicle. Note=Localizes at the cell membrane upon interaction with frizzled family members and promotes their internalization. Localizes to cytoplasmic puncta. |
| 翻译后修饰 | Phosphorylated by CSNK1D. |
| 相似性 | Belongs to the DSH family. Contains 1 DEP domain. Contains 1 DIX domain. Contains 1 PDZ (DHR) domain. |
| 功能 | Participates in Wnt signaling by binding to the cytoplasmic C-terminus of frizzled family members and transducing the Wnt signal to down-stream effectors. Promotes internalization and degradation of frizzled proteins upon Wnt signaling. Plays a role both in canonical and non-canonical Wnt signaling. Plays a role in the signal transduction pathways mediated by multiple Wnt genes. |
| 保存条件 | Shipped at 4℃. Store at -20℃ for one year. Avoid repeated freeze/thaw cycles. |
| 注意事项 | This product as supplied is intended for research use only, not for use in human, therapeutic or diagnostic applications. |
| 背景资料 | This gene encodes a member of the dishevelled (dsh) protein family. The vertebrate dsh proteins have approximately 40% amino acid sequence similarity with Drosophila dsh. This gene encodes a 90-kD protein that undergoes posttranslational phosphorylation to form a 95-kD cytoplasmic protein, which may play a role in the signal transduction pathway mediated by multiple Wnt proteins. The mechanisms of dishevelled function in Wnt signaling are likely to be conserved among metazoans. [provided by RefSeq, Jul 2008]. |
| 应用 | 推荐稀释比例 |
| {IHC-P} | {1:100-500} |
| {IHC-F} | {1:100-500} |
| {IF} | {1:100-500} |
Paraformaldehyde-fixed, paraffin embedded (human lung carcinoma); Antigen retrieval by boiling in sodium citrate buffer (pH6.0) for 15min; Block endogenous peroxidase by 3% hydrogen peroxide for 20 minutes; Blocking buffer (normal goat serum) at 37°C for 30min; Antibody incubation with (phospho-Dishevelled 2 (Thr224)) Polyclonal Antibody, Unconjugated (bs-9060R) at 1:400 overnight at 4°C, followed by operating according to SP Kit(Rabbit) (sp-0023) instructionsand DAB staining.
风险提示:丁香通仅作为第三方平台,为商家信息发布提供平台空间。用户咨询产品时请注意保护个人信息及财产安全,合理判断,谨慎选购商品,商家和用户对交易行为负责。对于医疗器械类产品,请先查证核实企业经营资质和医疗器械产品注册证情况。
技术资料暂无技术资料 索取技术资料
phospho-Dishevelled 2 (Thr224) Rabbit pAb(bs-9060R)-50ul/100ul/200ul
¥1180 - 2800





